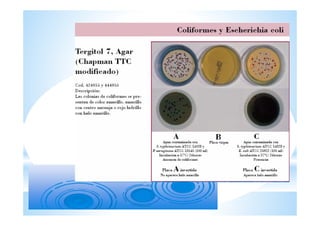
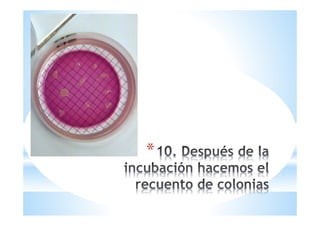
*

El documento describe los diferentes métodos para analizar la calidad microbiológica del agua, incluyendo la detección y cuantificación de bacterias coliformes, Escherichia coli, enterococos, Clostridium perfringens y bacterias aerobias. Explica los procedimientos de toma de muestras, transporte, análisis e interpretación de resultados para cada parámetro evaluado.